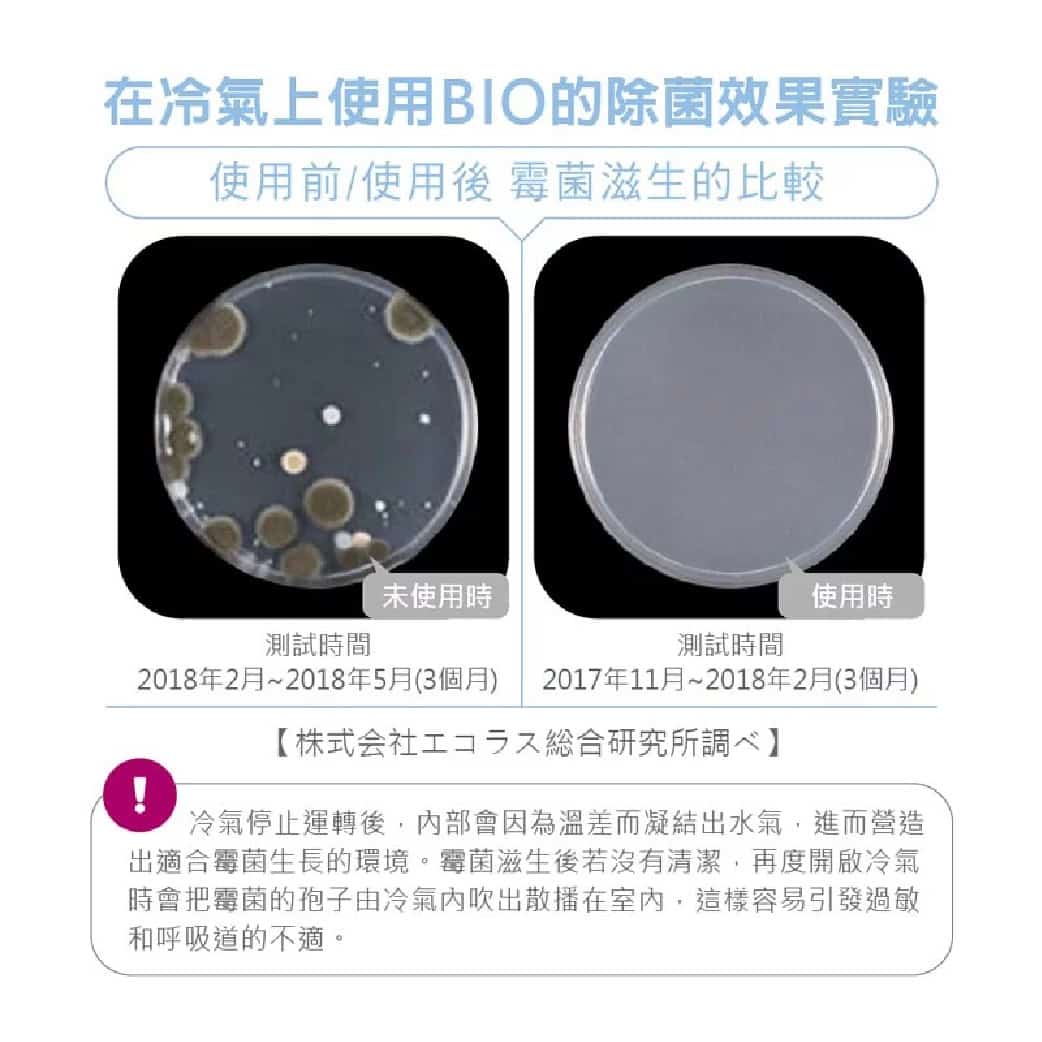
00497138_L_4_9240

Product Details
Sugi Power BioAnti Odour & Mold Deodorizer for Air Conditioner 1s | Long Lasting 3 Months Effect
Bio is microorganisms that cannot be seen with the naked eye.
They are alive and active everywhere on earth, including soil, water, plants, and air .
The Power Bio series is a cleaning item that uses the action of microorganisms to suppress mold and odors.
*Effects and replacement guidelines vary depending on the season, climate, environment of the installation location, and conditions. Product will not show instant effects.
Estimated replacement: Approximately 3 months
Installation location: Air conditioner intake
Estimated use per unit: 1 air conditioner
*We recommend that you clean the inside of the air conditioner before installing it.
*Be sure to install with the air conditioner turned off.
*Do not install on the air outlet. Protect your air conditioner from unpleasant mold and odors with [Power Bio for Air Conditioner], and use it comfortably with clean ventilation!
Made in Japan
SKU: 100202746
From the same brand
Sugi S Select Antibacterial Swab 200s X 2 | Clean Ear Canal By Removing Earwax
Sugi Cica Method Beauty 28ml Essence Facial Mask 3s | Intense Moisturizing
- Choosing a selection results in a full page refresh.
- Opens in a new window.